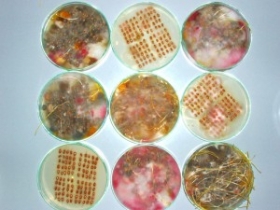

Mykologické analýzy
Zjištění spektra houbových mikroorganismů izolace a determinace houbových kultur.
Další dodavatelské nabídky
-
Doporučený záznam

-
Doporučený záznam

-
Doporučený záznam

-
Doporučený záznam

-
Doporučený záznam

-
Doporučený záznam

-
Doporučený záznam

-
Doporučený záznam

-
Doporučený záznam

-
Doporučený záznam

-
Doporučený záznam

-
Doporučený záznam